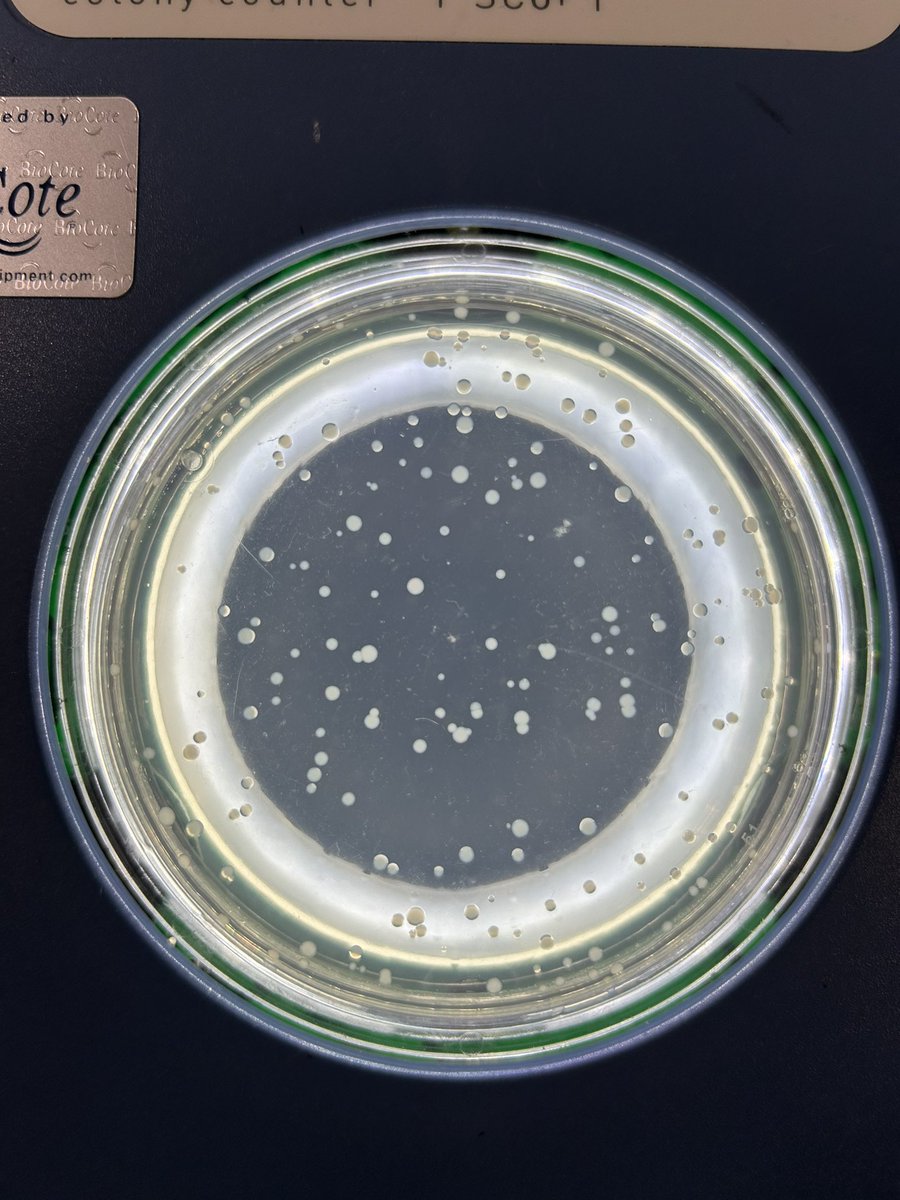
Aisling Brady tweet media

Sabitlenmiş Tweet
Kaitlin Schaal
223 posts


Kaitlin Schaal
@evokait
scientist, writer, rider, swordfighter. studying microbial eco-evo, experimental evolution, and microbial community interactions. she/her. 🏳️🌈.
Liverpool, England Katılım Mart 2015
178 Takip Edilen150 Takipçiler

Excited to announce our lovely new website showcasing the experimental evolution work with Myxococcus xanthus, a social and predatory soil bacterium. It's a great resource for anyone interested in microbial ecology/evolution or social evolution: myxoee.org
English
Kaitlin Schaal retweetledi


Check out my new preprint on how resource history impacts cheating and facultative exploitation in Myxococcus xanthus!
Ecological histories determine the success of social exploitation biorxiv.org/content/10.110…
with an AI summary: sciencecast.org/casts/paevzn7t…
English

@evokait Folks - how much is registration? I can't easily see online.
English

@chris_harrod GRS registration is $275, and GRC registration is $1,330
These fees are all-inclusive for the duration of the conference (hotel room and all meals included). Further info is available on the web pages under the "Conference Links" menu.
English
Kaitlin Schaal retweetledi
Kaitlin Schaal retweetledi


@directferries Great trip from Liverpool to Dublin! Very comfortable. So much less stressful than flying.
English

@directferries when I ask for help, the contact us form on the website doesn't recognize my email address, even though email address and booking reference are correct, and immediately closes the ticket. How can I get in touch?
English

@opodo prime @Opodo_UK @AmericanAir Bad weather in New York. Flight from BOS delayed 7hrs, then cancelled. Connecting flight missed. No one takes responsibility. Me - stranded, nowhere to sleep, no way to get home. This would never happen in the EU.
English

@opodo prime @Opodo_UK @AmericanAir Bad weather in New York - flight from BOS delayed 7hrs, then cancelled - flight to MAN missed. No one takes responsibility. Me - stranded, nowhere to sleep, no way to get home. This would never happen in the EU.
English

Verifying myself: I am kaschaal on Keybase.io. lnXS-A9iUdxF1c82MZgQDocabOfqBlCY_ZFt / keybase.io/kaschaal/sigs/…
English
Kaitlin Schaal retweetledi

We are looking for a motivated PostDoc to study with us how the metabolic and physiological states of bacteria influence their susceptibility to chemical compounds
jobs.unibas.ch/offene-stellen…
English